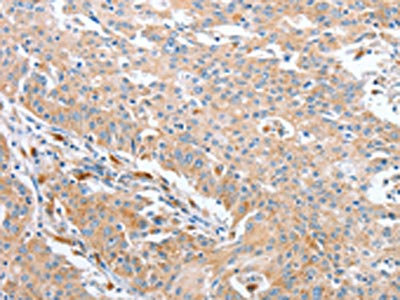

-
中文名稱:WNT3A兔多克隆抗體
-
貨號:CSB-PA560286
-
規格:¥1100
-
圖片:
-
The image on the left is immunohistochemistry of paraffin-embedded Human thyroid cancer tissue using CSB-PA560286(WNT3A Antibody) at dilution 1/40, on the right is treated with fusion protein. (Original magnification: ×200)
-
The image on the left is immunohistochemistry of paraffin-embedded Human gastric cancer tissue using CSB-PA560286(WNT3A Antibody) at dilution 1/40, on the right is treated with fusion protein. (Original magnification: ×200)
-
Gel: 8%SDS-PAGE, Lysate: 40 μg, Lane: Mouse lung tissue, Primary antibody: CSB-PA560286(WNT3A Antibody) at dilution 1/325, Secondary antibody: Goat anti rabbit IgG at 1/8000 dilution, Exposure time: 2 minutes
-
-
其他:
產品詳情
-
Uniprot No.:
-
基因名:
-
別名:Protein Wnt 3a Precursor antibody; Protein Wnt-3a antibody; Wingless type MMTV integration site family member 3A antibody; Wnt 3a antibody; wnt3a antibody; WNT3A protein antibody; WNT3A_HUMAN antibody
-
宿主:Rabbit
-
反應種屬:Human,Mouse
-
免疫原:Fusion protein of Human WNT3A
-
免疫原種屬:Homo sapiens (Human)
-
標記方式:Non-conjugated
-
抗體亞型:IgG
-
純化方式:Antigen affinity purification
-
濃度:It differs from different batches. Please contact us to confirm it.
-
保存緩沖液:-20°C, pH7.4 PBS, 0.05% NaN3, 40% Glycerol
-
產品提供形式:Liquid
-
應用范圍:ELISA,WB,IHC
-
推薦稀釋比:
Application Recommended Dilution ELISA 1:1000-1:2000 WB 1:200-1:1000 IHC 1:50-1:200 -
Protocols:
-
儲存條件:Upon receipt, store at -20°C or -80°C. Avoid repeated freeze.
-
貨期:Basically, we can dispatch the products out in 1-3 working days after receiving your orders. Delivery time maybe differs from different purchasing way or location, please kindly consult your local distributors for specific delivery time.
-
用途:For Research Use Only. Not for use in diagnostic or therapeutic procedures.
相關產品
靶點詳情
-
功能:Ligand for members of the frizzled family of seven transmembrane receptors. Functions in the canonical Wnt signaling pathway that results in activation of transcription factors of the TCF/LEF family. Required for normal embryonic mesoderm development and formation of caudal somites. Required for normal morphogenesis of the developing neural tube. Mediates self-renewal of the stem cells at the bottom on intestinal crypts (in vitro).
-
基因功能參考文獻:
- The miR-766-3p suppressed hepatocellular carcinoma (HCC) cell growth and invasion via a Wnt3a/PRC1 positive regulatory loop, and miR-766-3p may serve as a potential therapeutic target in HCC. PMID: 30145863
- High WNT3A expression is associated with colon cancer proliferation and metastasis. PMID: 29948330
- Wnt3A regulates the expression of 1,136 genes, of which 662 are upregulated and 474 are downregulated in CCD-18Co cells. A set of genes encoding inhibitors of the Wnt/beta-catenin pathway stand out among those induced by Wnt3A, which suggests that there is a feedback inhibitory mechanism. PMID: 29044515
- PCR and western blot results showed that inhibiting the secretion of Wnt3A blocked the Wnt signaling pathway and prevented Nrf2 signaling. Notably, the Wnt inhibitor may serve as a radiosensitizing drug PMID: 28627706
- Study found that Wnt3a highly expressed in hepatocellular carcinoma (HCC) tissues, and confirmed that Wnt3a plays an essential role in HCC progression. Activation of the Wnt3a pathway is accompanied by higher expression of Notch3. Furthermore, Wnt3a may be critical for HCC cell cycle and metastasis by regulating cell cycle regulatory proteins and the MAPK pathway. PMID: 28902357
- WNT3A supports early stages such as the ALP activity, but it does neither improve later stages of the osteogenic differentiation nor it inhibits the genuine adipogenic differentiation of adipose tissue derived mesenchymal stem cells. PMID: 28549605
- SP5 negatively regulates WNT3a transcriptional programs in human pluripotent stem cells. PMID: 29044119
- Suggest that GPC5 is able to suppress the lung adenocarcinoma metastasis by competitively binding to Wnt3a and inactivating the Wnt/beta-catenin signaling pathway. PMID: 27806326
- WNT3A/beta-catenin signaling inhibition is involved in leflunomide-mediated cytotoxic effects on renal carcinoma cells PMID: 27391060
- BRG1 may contribute to colon cancer progression through upregulating WNT3A expression. PMID: 27852072
- Here we describe a one-step immobilization technique to covalently bind WNT3A proteins as a basal surface with easy storage and long-lasting activity. We show that this platform is able to maintain adult and embryonic stem cells while also being adaptable for 3D systems PMID: 27411105
- study reveals that Foxi1/miR-491-5p/Wnt3a/beta-catenin signaling is critical in the progression of GC. Targeting the pathway described in this study may open up new prospects to restrict the progression of gastric cancer PMID: 28358374
- CHIR suppressed the hypertrophic propensity of the MSC-derived cartilage after in vivo implantation to an extent approaching that of WNT3A protein. These results indicate that CHIR may be a promising alternative for WNT3A protein for certain applications of human bone marrow-derived MSCs. PMID: 27633010
- PEGylated Wnt3A liposomes associated with skeletal stem cell populations in human bone marrow and promoted osteogenesis. PMID: 28351228
- The AChE plays a role in osteoblastic differentiation and is regulated by both Wnt3a and Runx2. PMID: 28607150
- In promoting the self-renewal symmetric division of hTERT(high) prostate cancer cells, WNT3a dramatically decreased the ratio of hTERT(high) prostate cancer cells undergoing asymmetric division. Increased WNT/beta-catenin signal activation was also detected in hTERT(high) prostate cancer cells. hTERT-mediated CSC properties were at least partially dependent on beta-catenin. PMID: 28209613
- the results indicate neighboring structural elements within full-length Wnt3a affect saposin-like subdomain (SLD) conformational stability. Moreover, SLD function(s) in Wnt proteins appear to have evolved away from those commonly attributed to SAPLIP family members. PMID: 28754322
- CPE through its N'-terminal sequence, forms aggregates with Wnt3a and possible endoplasmic reticulum (ER) stress leading to its loss of function. PMID: 27375026
- Our findings suggest that Pyk2 plays an important role in the coordination of stabilization of beta-catenin in the crosstalk between Wnt/beta-catenin and Wnt/Ca(2+) signaling pathways upon Wnt3a stimulation in differentiating hNPCs. PMID: 28694190
- Macrophage polarization seems to have a key role in the progression of pediatric non-alcoholic fatty liver disease; the modulation of macrophage polarization could drive hepatic progenitor cell response by Wnt3a production and beta-catenin phosphorylation. PMID: 27310371
- this study shows that Wnt3a promotes differentiation of dendritic cells, but inhibits their maturation PMID: 27641635
- Taken together, our results suggest that canonical Wnt signaling and its antagonist, sFRP1, regulate proliferation of human CSCs. Furthermore, excess sFRP1 in elderly patients causes CSC aging. PMID: 28435069
- Thus, our findings provide mechanistic insight into the proposed cross-talk between the Wnt/beta-catenin and Hippo pathways in androgen-independent prostate cancer development. PMID: 28366633
- TGF-beta1 signaling might have roles in myofibroblast differentiation in response to orthodontic force. We reveal in vitro that both Wnt3a and TGF-b1 promote myofibroblast differentiation from human periodontal ligament cells PMID: 28223136
- Furthermore, pigment epithelium-derived factor (PEDF), a secreted glycoprotein known for its anti-tumor properties, blocked Wnt3a-directed induction of autophagy proteins. Autophagy inhibition was complemented by reciprocal regulation of the oxidative stress enzymes, superoxide dismutase 2 (SOD2) and catalase. PMID: 27557659
- we performed a rescue experiment in the JB6 cell line and found that the inhibitory effect of Wnt5a on cell proliferation could be rescued by the addition of Wnt3a. Our data reveal that Wnt5a suppresses the activation of b-catenin signaling during hair follicle regeneration. PMID: 27499692
- The level of Wnt3a expression in hepatocellular carcinoma(HCC) patients was obviously higher than that in any group of cases with benign liver diseases. The diagnostic specificity or the area under the receiver operating characteristic curve was 94.34 % or 0.994 in Wnt3a and 69.81 % or 0.710 in AFP for HCC, respectively. PMID: 26577850
- Oncogenic Wnt3a expression associated with HBV infection and cirrhotic liver might be an independent prognostic factor for hepatocellular carcinoma. PMID: 27076768
- AurkA suppresses the expression of miR-128, inhibitor of wnt3a mRNA stabilization. PMID: 27341528
- The pool of ADP-ribosylated Axin, which is degraded under basal conditions, increases immediately following Wnt stimulation in both Drosophila and human cells. PMID: 27138857
- The results reveal a novel inhibitory role of Wnt3a on canonical Wnt/beta-catenin signaling and cancer cell proliferation when there is an insufficient blood supply during tumor development. PMID: 26643293
- Upregulated Wnt3a in colon cancer cells promoted the capacity to form tube-like structures in the three-dimensional (3-D) culture together with increased expression of endothelial phenotype-associated proteins such as VEGFR2 and VE-cadherin. PMID: 26266404
- 72 Wnt target genes higher expressed in triple-negative breast cancer PMID: 25848952
- a Wnt-amplified environment was associated with superior pulp healing. PMID: 25556760
- Wnt3a can modulate intracellular localisation and secretion of sFRP4. PMID: 25805505
- These observations demonstrated the first time that Wnt3a can directly activate MyoD expression through targeting cis-elements in the DE and the L fragment. PMID: 25651906
- Wnt-mediated protein stabilization ensures proper mitotic microtubule assembly and chromosome segregation. PMID: 25656539
- Wnt3a expression was associated with epithelial mesenchymal transition and promoted colon cancer progression. PMID: 25499541
- Wnt3a and Notch3 may promote the metastasis of non-small cell lung cancer and Notch3 upregulation is required for the Wnt3a mediated increased metastatic abilities of non-small cell lung cancer. PMID: 25572698
- SNP rs752107 in WNT3A was strongly associated with decreased total hip BMD showing the highest significance under the recessive model PMID: 24584697
- miR-195 is key in regulating cell proliferation, cell cycle and apoptosis through targeting Wnt3a. PMID: 25174704
- WNT3A alone was a poor inducer of mesoderm from hESCs in defined medium. WNT3A and BMP4 synergized to accelerate mesoderm formation. Added later, WNT3A blocked hematopoiesis and generated mesenchymal colonies. PMID: 24052942
- High WNT3A expression is associated with glioblastoma. PMID: 25301448
- WNT3A gene expression is associated with isolated Hirschsprung disease polymorphism and disease status. PMID: 24817932
- High WNT3A expression is associated with bone destruction in lung and breast cancer. PMID: 25359619
- High Wnt3A expression is associated with metastasis in triple negative breast cancer. PMID: 24209998
- Application of recombinant Wnt3a showed an anti-proliferative effect on keratinocytes in a dose-dependent manner. PMID: 24686518
- these results show that TAZ mediates Wnt3a-stimulated osteogenic differentiation through PP1A, suggesting that the Wnt signal regulates the Hippo pathway. PMID: 24510127
- The LRP6 tyrosine mutant increased in signaling activation in response to Wnt3a/beta-catenin stimulation. PMID: 25143377
- p66(Shc) plays a vital part in canonical Wnt signaling in the endothelium and mediates Wnt3a-stimulated endothelial oxidative stress and dysfunction. PMID: 25147340
顯示更多
收起更多
-
亞細胞定位:Secreted, extracellular space, extracellular matrix. Secreted.
-
蛋白家族:Wnt family
-
組織特異性:Moderately expressed in placenta and at low levels in adult lung, spleen, and prostate.
-
數據庫鏈接:
Most popular with customers
-
Phospho-YAP1 (S127) Recombinant Monoclonal Antibody
Applications: ELISA, WB, IHC
Species Reactivity: Human
-
-
-
-
-
-
-
VDAC1 Recombinant Monoclonal Antibody
Applications: ELISA, WB, IHC
Species Reactivity: Human, Mouse, Rat